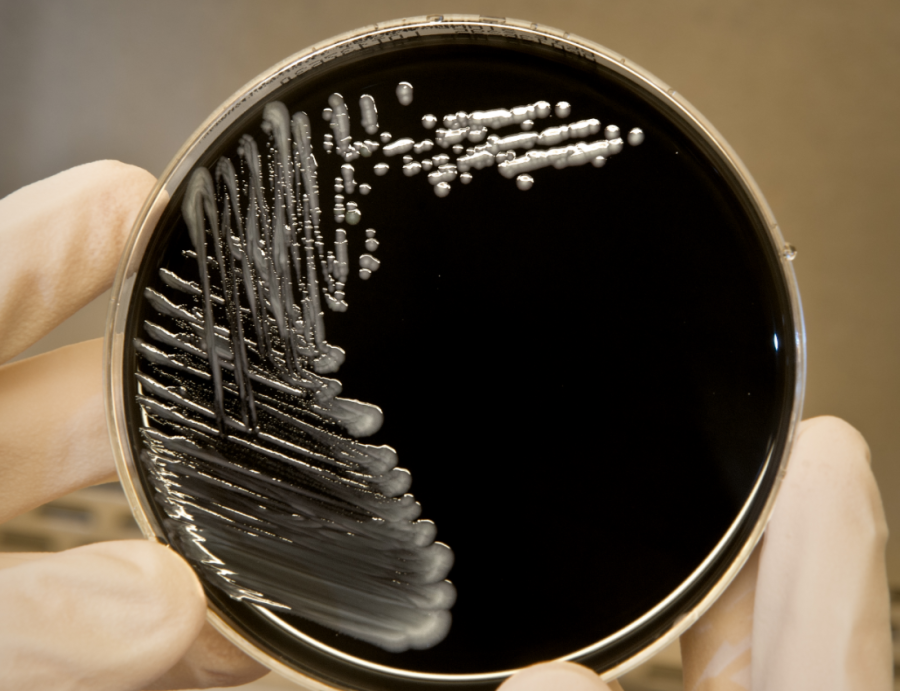
A legionella baktérium a langyos vízben szaporodik el

A szökőkútban fürdés minden bizonnyal nem mai találmány, bár régebben mintha furcsábban néztünk volna azokra, akik strandnak használják ezeket a látványelemeket. Mára valamiért eljutottunk oda, hogy szülők és nagyszülők a legnagyobb természetességgel engedik csemetéiket a vízfüggönybe, és még jóízűen kacarásznak is rajta, hogy milyen cukin pancsol a gyerek.
Azzal nem mondok újdonságot, hogy a szökőkutak vize – ellenben az ivókutakkal – emberi fogyasztásra alkalmatlan, de ez persze még nem zárja ki, hogy egy frissítő zuhany erejéig belegyalogoljunk. Végül is, mi bajunk lehet?
Mindenféle.
Kezdjük azzal, hogy a fürdésre tervezett létesítményeknek szigorú előírásoknak kell megfelelniük annak érdekében, hogy a felhasználók ne fertőzzék meg egymást mindenféle betegséggel, vagy az embertől függetlenül a vízben élő baktériumok ne tudjanak elszaporodni. Nyilván a szökőkutak vizét is tisztítják, fertőtlenítik, azonban nincs meg az a fokozott napi szintű karbantartás, amit a strandokon elvégeznek kifejezetten azért, hogy fürdésre alkalmas legyen a közeg.
Ne feledjük: a szökőkút vizével nemcsak mi érintkezünk, más emberek, a városban élő állatok (kutyák, macskák, galambok) is, és minden mocsok, amit a járdáról a víz összemos és gejzírszerűen fellő.
A kánikulában felmelegedő víz tökéletes élettér a baktériumok számára, amik több úton is okozhatnak galibát. Bőrbetegséget, a szembe kerülve kötőhártya-gyulladást okozhatnak, lenyelve emésztőrendszeri bántalmakat, hasmenést válthatnak ki. A szökőkutakban elszaporodhatnak a legionella baktériumok, amiket a vízpermettel belélegezhetünk, és a tüdőnkön megtapadva súlyos tüdőgyulladást okozhatnak. Ezek ugyanazok a baktériumok, amik a légkondiból is a szervezetünkbe kerülhetnek, ha a téli állás után nem fertőtlenítjük a rendszert.
Természetesen a szökőkutak üzemeltetői mindent elkövetnek azért, hogy elkerüljék az efféle megbetegedéseket, de talán érdemes lenne nekünk is elgondolkoznunk azon, hogy a gyereket tényleg olyan cuki dolog-e a szökőkútban strandoltatni.